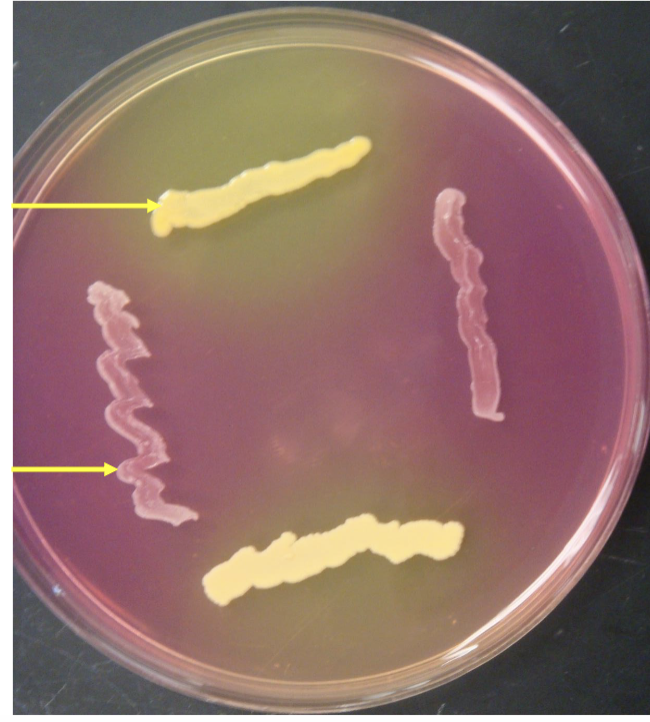
<p>what’s the selective agent?</p><p>only …. bacteria grow</p>
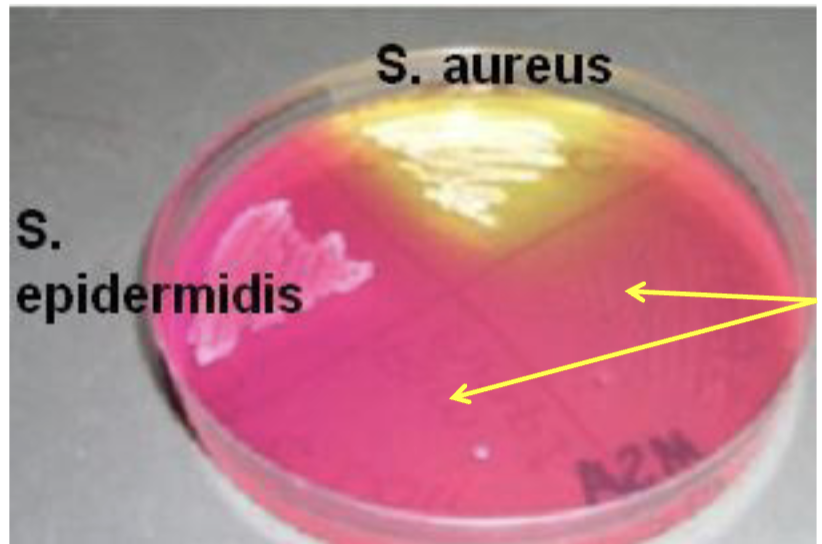
<p>bottom yellow arrows is what? no ….not …. ….</p>
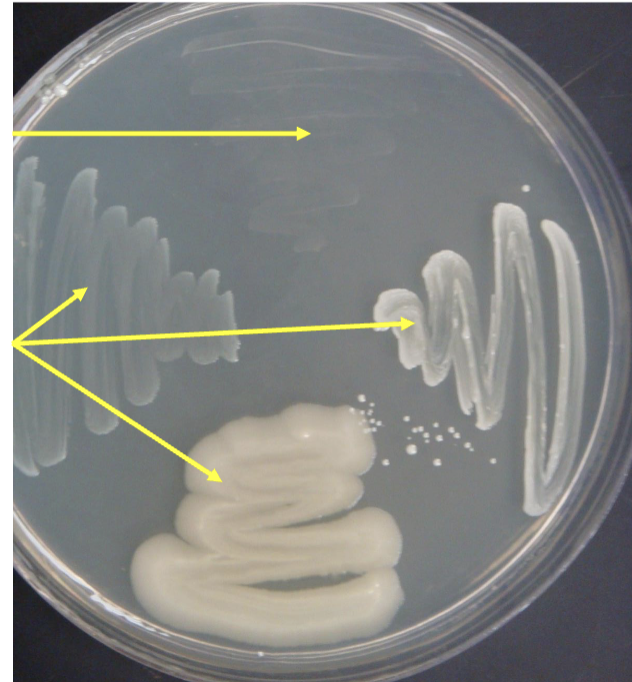
<p>what type of agar is this?</p>
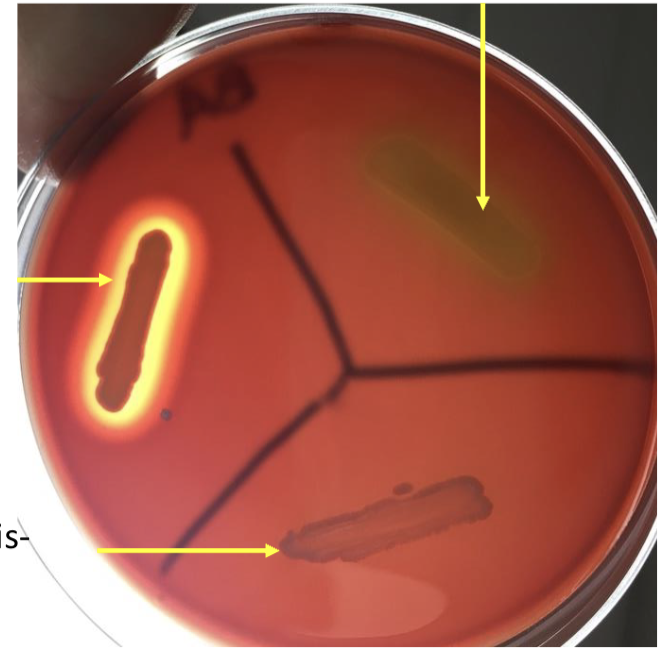
<p>what <strong>type</strong> of agar? s or d?</p>
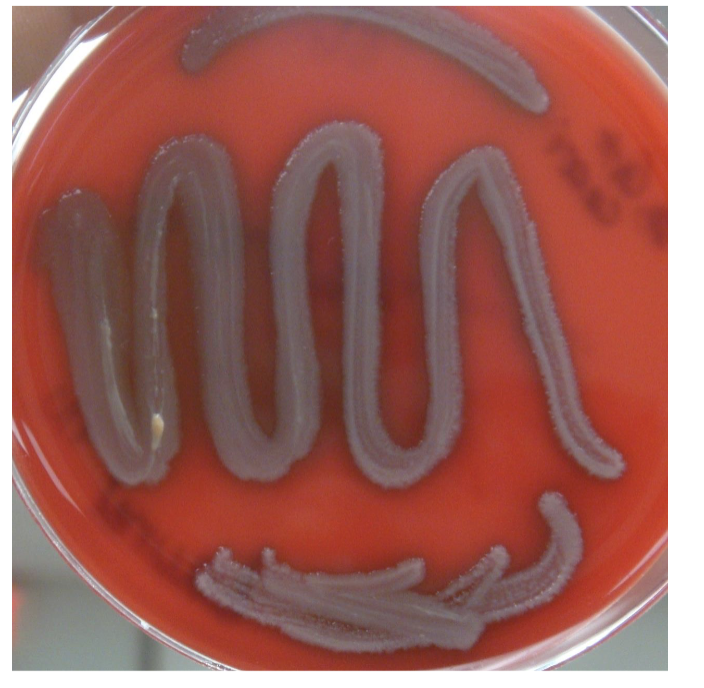
<p>name bacteria that is <strong>gamma</strong> hemolysis?</p>
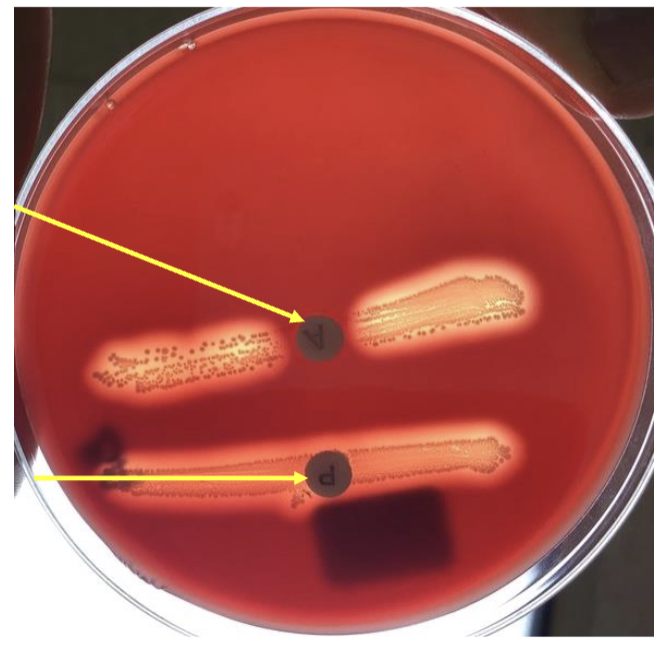
<p>what bacteria is this?</p>
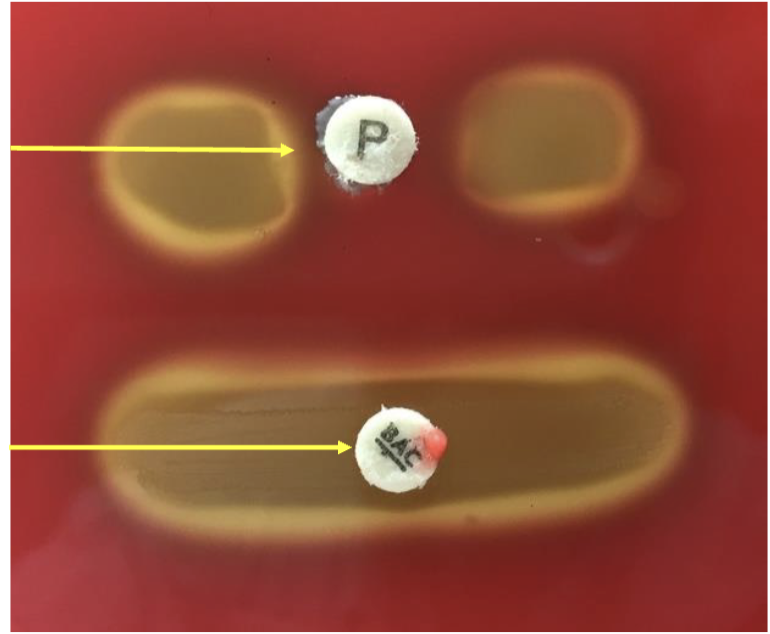
<p>what happened to p?</p>

micro LAB TEST NOW pt.2
1/83
There's no tags or description
Looks like no tags are added yet.
Name | Mastery | Learn | Test | Matching | Spaced | Call with Kai |
|---|
No analytics yet
Send a link to your students to track their progress
84 Terms

what’s this?
mannitol salt agar

what’s the ph?
phenol red

what type of agar? s or d or both?
selective and differential agar
what’s the selective agent?
only …. bacteria grow
salt

whats the differential agent?
mannitol

what bacteria do with mannitol? some … …. bacteria …. mannitol or …
some salt tolerant bacteria ferment mannitol or not

if it’s yellow it;s?… …. and. …. ….
salt tolerant and ferments mannitol

yellow bacteria?
Staphylococcus aureus

if not yellow it’s what?pink/red/clearish
… …. but does … … ….
salt tolerant but does not ferment mannitol

that is not yellow? bacteria NAME
staphylococcus epidermis
bottom yellow arrows is what? no ….not …. ….
no growth not salt tolerant

bacteria NAME GENUS SPECIES that does not grow?
streptococcus pyogenes

what’s this?
phenylethyl alcohol agar
what type of agar is this?
selective agar

selective agents?
phenylethyl alcohol

phenylethal alcohol inhibits who?
gram negative bacteria

if it grows it’s? bottom arrows staph. aureus
gram positive bacteria

top arrow if it doesnt grow its? + or -
gram negative bacteria

PEA does what?….,….,….
inhibits growth, reduces growth does not kill

what is this?
blood agar

what. type of blood?
5% sheep blood
what type of agar? s or d?
differential agar

what’s the differential agent?
blood

what’s a hemolysis?
red blood cell break down

what does the hemolysin enzyme do?
break down red blood cells

if there’s a clearing in blood and transparent it’s?
beta hemolysis

if it’s partial clearing in blood it’s?
alpha hemolysis

no effect on blood it’s?
Gamma hemolysis

name a baceria that is BETA?
streptococcus pyogenes

alpha hemolysis bacteria?
streptococcus pneumoniae
name bacteria that is gamma hemolysis?
staphylococcus epidermis

what’s this?
staphytect plus agglutination test

what is the test for?
antigen and antibody reaction

where are the antibodies on? bacteria name …., antibodies in …..
staphylococcus aureus antibodies in reagent

where are the antigens on?
…. on …. of …. bacteria name
antigens on surface of staphylococcus aureus

if we mix antigens and antibodies what happens?
antigens bind compatable antibodies

if there’s clumping it’s? +or-?
positive

if no clumping? +or-?
negative

+ bacteria?
staphylococcus aureus

- bacteria?
staphylococcus epidermis

were trying to find?
staphylococcus aureus

what’s this?
catalase test

we are trying to distuinguish?….., from……,……
Staphylococcus from Streptococcus and Enterococcus

what’s the substrate?
h2o2 hydrogen peroxide

enzyme?
catalase

what does enzyme do?
catalase break down hydrogen peroxide into water and oxygen

product?
oxygen and water

if no bubbles it’s? + or - no … … …
negative no oxygen was form

if bubbles it’s ?
positive forms oxygen

what’s a negative bacteria for catalase
streptococcus

what’s positive bacteria for catalase?
staphylococcus
what bacteria is this?
streptococcus pyogenes

what is A name?
bacitracin

what is p name?
optochin

what happened to A?
no growth around disc, sensitivity

what happened to p disc?
growth around disc, resistant

who is p resistant?
streptococcus pyogenes

who is A sensitive?
streptococcus pyogenes

what hemolysis? s.p
beta hemolysis

what bacteria is this?
Streptococcus pneumoniae
what happened to p?
no growth around disc, sensitive

what happened to bac/ A?
growth around disc, resistant

what hemolysis is this?
alpha hemolysis

what is this?
bile esculin

is it h2s?
NO

what type of agar? s or d or both
selective and differential agar

what is the selective agent?
bile

what is the differential agent?
esculin

black on slant is? + or -
positive

not black means? + or -
negative

black color bacteria +? 2 bacteria
streptococcus bovis, Enterococcus faecalis

not black - bacteria name?
streptococcus pyogenes

what is this? name
6.5% salt broth

what are halophiles?
salt tolerant

what type of agar is it?
selective agar

selective agent?
salt

left tube is what?+ or -
turbid-positive
salt tolerant

if it’s transparent it’s? + or - and … … …
negative not salt tolerant

name left side + bacteria?
enterococcus faecalis

Salt affects … across cell membrane
establishes hypertonic environment
water moves out of cell
osmotic gradient

whos BE positive
6.5% salt- positive?
Enterococcus faecalis
whos BE positive
6.5% salt- negative?
Streptococcus bovis


what bacteria is sensitive to novobiocin ?BA
staphylococcus aureus

what bacteria is resistant to novobiocin sensitivity?BA
staphylococcus saprophyticus